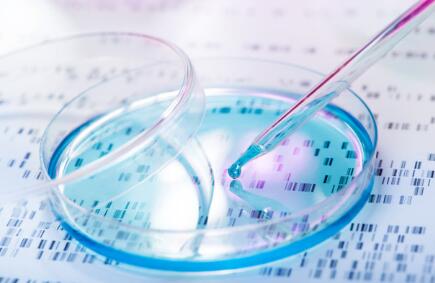
親子鑒定用什么材料 親子鑒定用什么材料

做親子鑒定用什么材料
做親子鑒定用什么材料?不同DNA親子鑒定對被鑒定人的要求不同,準備的東西也不一樣。DNA親子鑒定分為個人親子鑒定和司法親子鑒定。
做個人親子鑒定需要準備哪些材料
做個人親子鑒定只需要準備樣本即可,需要保證自己采集的樣本可用,DNA含量豐富且不被污染。
個人親子鑒定可供選擇的樣本有血液、血痕、口腔拭子、毛發、煙蒂、指甲、牙刷、口香糖、精液、精斑、經血、流產物、骨骼等,只要是含有細胞核的細胞都能做個人親子鑒定。
做司法親子鑒定需要準備哪些材料
1、所需證件:如身份證、護照、軍官證、戶口簿或者孩子的出生證),包括原件和復印件。如果沒有上述這些證件需要到當地派出所、公安局出具的親子鑒定申請證明。
2、可提供的樣本:血液、口腔拭子。
另外,做司法親子鑒定需要被鑒定人親自到鑒定中心辦理實名委托,留指紋、拍照等相關手續。
DNA親子鑒定中心溫馨提示:個人親子鑒定不具有法律效力,只能個人參考使用。司法親子鑒定具有法律效力,可以用來上戶口、移民、留學、打官司等等。
DNA親子鑒定中心是具有法醫物證司法鑒定資質的正規司法鑒定機構,擁有占地1500平方米的獨立實驗室,最新型的實驗器材和試劑,獨立完成各種類型的DNA親子鑒定,保證鑒定結果的有效性和準確性。
標簽:親子鑒定用什么材料


微信掃碼咨詢預約